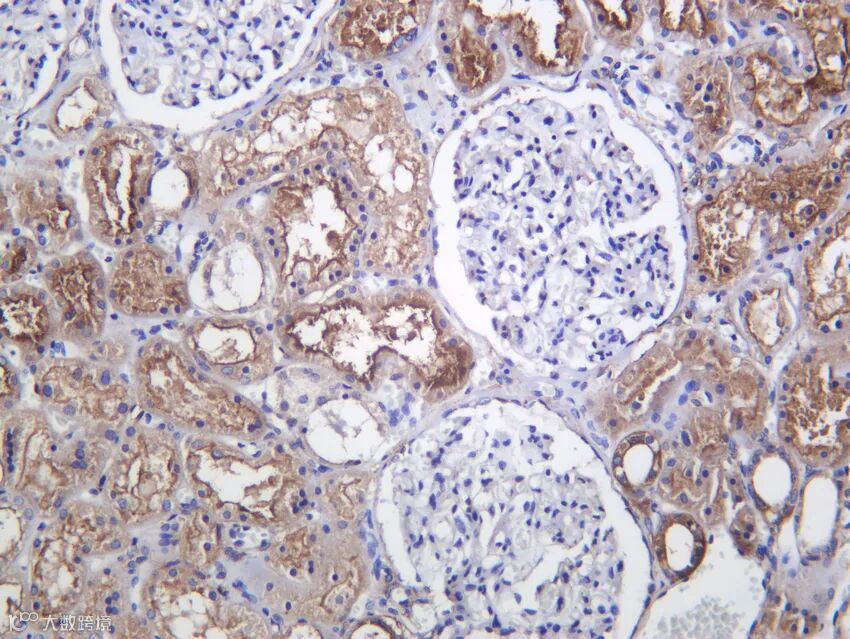
d2ad4910487150530574c68aca89a30b_RX1533-PT1265R-Human+kidney.jpg

Immunoway的兔重组基因工程抗体——PT™ Rabbit mAb 研发平台拥有四重特异性筛选环节,以确保抗体的高度特异性和高亲和力。
首先用特异性多肽或者真核蛋白对兔子进行免疫,刺激其免疫系统产生特异性抗体,抽取血液做内源性样本的特异性检测和血清效价的检测;
在B细胞筛选过程中,通过双阳性流式细胞分选,分离出B细胞表面IgG+和抗原特异性+的B细胞;
然后对单B细胞进行培养,并通过Elisa、IHC、WB、IF等实验对阳性B细胞进一步进行特异性筛选鉴定;
将筛选出的B细胞中的抗体可变区基因进行克隆与重组,将重组抗体基因导入哺乳动物细胞中进行表达,再通过如Elisa、WB、IHC、IF、FCM、IP等全面特异性验证方式进行检测;
最后通过细胞培养、抗体表达和纯化等步骤,获得高纯度的兔重组基因工程抗体。

MYH10 (PT1265R) PT™ Rabbit mAb
Reactivity:Human, Mouse, Rat
Applications:WB, IHC, IF, IP, ELISA

关键词:非肌球蛋白重链、细胞迁移、神经发育
MYH10(非肌球蛋白 IIB 重链)是 II 型肌球蛋白家族成员,在非肌细胞中形成双极纤维,通过水解 ATP 产生收缩力,调控细胞黏附、迁移、胞质分裂及神经元生长锥导向。在胚胎发育中,MYH10 对心脏和神经系统形成至关重要;成年后主要在脑、免疫细胞中表达。其功能缺失可导致神经发育障碍。本抗体跨物种识别 MYH10,支持 IP 验证肌球蛋白复合物,是细胞运动与发育生物学研究的核心试剂。

Cbl (PT1261R) PT™ Rabbit mAb
Reactivity:Human, Mouse, Rat
Applications:WB, IHC, IF, IP, ELISA


关键词:E3泛素连接酶、受体酪氨酸激酶调控、信号负反馈
Cbl(Casitas B-lineage lymphoma)是 RING 型 E3 泛素连接酶,通过泛素化修饰活化的受体酪氨酸激酶(如 EGFR、c-Met、PDGFR)及其下游适配蛋白,促进其内吞与溶酶体降解,从而负调控生长因子信号。Cbl 功能缺失突变见于髓系白血病和实体瘤,导致信号通路持续激活。本抗体跨物种识别 Cbl 全长蛋白,支持 IP 验证其与底物互作,是 RTK 信号调控研究的核心试剂。

COX5A (PT1270R) PT™ Rabbit mAb
Reactivity:Human, Mouse, Rat
Applications:WB, IHC, IF, IP, ELISA


关键词:线粒体呼吸链、细胞色素c氧化酶、能量代谢
COX5A 是线粒体电子传递链复合物 IV(细胞色素 c 氧化酶)的核编码亚基,参与催化电子从细胞色素 c 向氧气的最终传递,驱动质子泵送与 ATP 合成。其表达受氧浓度调控(低氧下被 COX5B 替代),是线粒体功能完整性的关键指标。COX5A 缺陷可导致 Leigh 综合征等线粒体病。本抗体跨物种适用,支持多平台检测,广泛用于代谢与衰老研究。

LYPLA1 (PT1669R) Rabbit mAb
Reactivity:Human, Mouse, Rat
Applications:WB, IHC, IF, ELISA

关键词:棕榈酰硫酯酶、蛋白质去棕榈酰化、信号膜定位
LYPLA1(Lysophospholipase A1)是一种丝氨酸水解酶,主要催化蛋白质 S-棕榈酰化修饰的去除,调控 Ras、Src、G 蛋白等信号分子在质膜与胞内囊泡间的动态定位。其活性影响 Wnt、Hedgehog 等通路的信号强度。LYPLA1 在神经系统和免疫细胞中高表达,与神经发育及炎症调控相关。本抗体适用于多平台检测,是蛋白质脂修饰动态研究的重要工具。

FGFR-3 (PT1552R) PT™ Rabbit mAb
Reactivity:Human, Mouse, Rat
Applications:WB, IHC, IF, ELISA

关键词:成纤维细胞生长因子受体、软骨发育、膀胱癌
FGFR3 是 FGF 受体家族成员,在骨骼发育中抑制软骨细胞增殖,其激活突变导致侏儒症(如软骨发育不全)。在成人中,FGFR3 在膀胱尿路上皮癌中高频突变或融合,驱动肿瘤生长;也在多发性骨髓瘤中异常表达。靶向 FGFR3 的抑制剂(如 erdafitinib)已获批用于晚期膀胱癌。本抗体跨物种识别 FGFR3,适用于 IHC 评估肿瘤表达,助力靶向治疗研究。

HSP10 (PT1626R)Rabbit mAb
Reactivity:Human, Mouse, Rat
Applications:WB, IHC, IF, IP, ELISA

关键词:线粒体分子伴侣、HSP60/HSP10复合物、蛋白质折叠
HSP10 与 HSP60 形成桶状复合物,作为线粒体基质中的分子伴侣,协助新导入或应激变性蛋白的正确折叠与组装。该系统对维持线粒体蛋白稳态至关重要。HSP10 表达异常与 Leigh 综合征、心肌病及某些癌症相关。此外,HSP10 可分泌至胞外发挥免疫调节作用。本抗体跨物种识别 HSP10,支持 IP 验证 HSP60/10 互作,是线粒体质量控制研究的重要试剂。

新品速递

| 货号 | 名称 | 规格 |
TROP2 (PT1308R) PT™ Rabbit mAb |
40μL/100μL/200μL |
|
SOX1 (PT1254R) PT™ Rabbit mAb |
40μL/100μL/200μL |
|
Src (Phospho Tyr529)(PT1540R) PT™ Rabbit mAb |
40μL/100μL/200μL |
|
FOLR1 (PT1605R) PT™ Rabbit mAb |
40μL/100μL/200μL |
|
PER3 (PT1614R)PT™ Rabbit mAb |
40μL/100μL/200μL |
|
TPO (PT1620R) PT™ Rabbit mAb |
40μL/100μL/200μL |
|
GBP1 (PT1665R) PT™ Rabbit mAb |
40μL/100μL/200μL |
|
Peroxiredoxin-2 (PT1624R) PT™ Rabbit mAb |
40μL/100μL/200μL |
|
KDM6A/UTX (PT1584R) PT™ Rabbit mAb |
40μL/100μL/200μL |
|
SOCS-1 (PT1632R) PT™ Rabbit mAb |
40μL/100μL/200μL |
|
NCoA-3 (PT1635R) PT™ Rabbit mAb |
40μL/100μL/200μL |
|
CYLD (PT1640R) PT™ Rabbit mAb |
40μL/100μL/200μL |
|
IGJ (PT1675R) PT™ Rabbit mAb |
40μL/100μL/200μL |
|
SH2B3 (PT1676R) PT™ Rabbit mAb |
40μL/100μL/200μL |
|
VAV1 (PT1677R) PT™ Rabbit mAb |
40μL/100μL/200μL |
|
PKD2 (PT1685R) PT™ Rabbit mAb |
40μL/100μL/200μL |
|
ZNFX1 (PT1618R) PT™ Rabbit mAb |
40μL/100μL/200μL |
|
UBC12 (PT1625R) PT™ Rabbit mAb |
40μL/100μL/200μL |
- END -
About
关于睿捷生物科技有限公司
睿捷生物科技有限公司是 (realgen-bio Co., Ltd.,简称睿捷生物)致力于为国内生命科学领域提供先进、专业的仪器设备、试剂耗材的企业。公司目前是近20家国内外知名生物公司的一级代理商,为客户提供从研发到生产的各类实验室仪器,检测试剂和生产设备。
公司产品领域涵盖分子生物学、免疫学、血液学、肿瘤研究、信号通路、药物筛选、干细胞研究、神经生物学、表观遗传学等等,为用户提供系统性的科学研究完整解决方案,成为众多研究者们可以信赖的选择。
公司成立于2011年,总部位于苏州,在南京、济南、合肥都设有办事处,公司客户主要为国内领先的生物制药、细胞治疗、生物医学和各类生物技术公司,以及大量的生命科学基础研究和政府实验室,目前已服务客户单位4000余家。

睿捷-企业文化
公司的使命:高效服务客户、为客户持续创造价值
公司的愿景:将人与科技相结合,成为生命科学领域一流的解决方案供应商
公司的价值观:诚信、公开、坚持、分享
睿捷-合作伙伴













